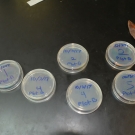
Students at Forest Heights Academy label their agar plates so that they can later check their plates after 3 days, 1 week, and 2 weeks to see if there is any type of fungus growing.
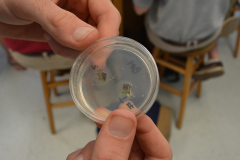
Plated leaf cuttings
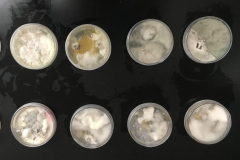
Fungus growing on agar growth plates

You are here:
- Home
- Amy Heemsoth
![]()
Amy Heemsoth
Chief Operating Officer & Director of Education
Bio
Amy Heemsoth is an accomplished professional serving as the Chief Operating Officer (COO) and Director of Education for the Khaled bin Sultan Living Oceans Foundation. With her dual role, Amy plays a crucial role in overseeing the Foundation’s internal operations as the COO, while also leading the development of innovative education projects and programs as the Director of Education. She focuses on creating engaging learning experiences for K-12 students, teachers, non-formal educators, and communities.
Amy’s educational journey began at Spring Hill College, where she earned a bachelor’s degree in marine biology. Building on her passion for marine life, she pursued a master’s degree in marine biology from Nova Southeastern University, with her research focusing on the diet composition of swordfish in the Florida Straits.
With over 20 years of teaching experience, Amy has made an impact in formal and non-formal education. She has held positions at institutions such as MarineLab and Seacamp, renowned for their dedication to outdoor marine education. Amy’s ability to inspire and engage students led her to teach high school math and science and serve as a community college adjunct professor.
Amy’s commitment to community engagement and education extends beyond the classroom. Before joining the Foundation, she served as the Education and Outreach Coordinator for Florida International University, where she actively engaged with the Florida Keys community through various outreach activities. Amy also gained valuable experience educating the public about coral reefs during her work on snorkel/dive vessels in the Great Barrier Reef, Australia. With her diverse background and expertise, Amy is committed to sharing knowledge and fostering a deep understanding of our oceans, which is instrumental in raising awareness and inspiring action to preserve our marine ecosystems.
Missions
Photos
-

10th grade student at Forest Heights Academy collects three red mangrove seedlings that she will grow and care for during the next eight months in her Biology class.
-

Forest Heights student takes an initial growth measurement of her mangrove seedling. She and her classmates will continue to measure the growth of each seedling over the next 8 months.
-

Before placing their seedlings in a plant flat, they measure their seedlings, so they can track their growth over time.
-

Students at Forest Heights Academy plant their mangrove propagules in the plat flat filled with pebbles.
-

B.A.M. participant determines which grid he put his mangrove propagule in so he can correctly identify it the next time he needs to measure it.
-

Students at Forest Heights Academy place their mangrove propagules in the sand flat.
-

This student takes the first measurement of his mangrove seedling. He will record this data in his mangrove journal.
-

Biology student at Forest Heights Academy has measured his propagule and he is now going to plant it in the flat filled with sand.
-

I wonder which type of media the students' mangrove seedlings will grow best in: mangrove mud, sand, or pebbles?
-

Students plant their mangrove seedlings in mud.
-

Ready to Grow - Mangrove seedlings in sand
-

Forest Heights Academy B.A.M. participant writes down observations about his seedlings.
-

It looks like this Forest Heights Academy student is finished adding sand to this plant flat. We are now ready to plant the seedings.
-

The third type of media, sand, is being placed in a plant flat by a Forest Heights Biology student.
-

Safety in Numbers - You never know when you might get stuck in the mud, so it's best to bring a friend to help you out.
-

Biology students look for healthy red mangrove propagule.
-

It looks like these students from Forest Heights Academy have found more than enough mangrove seedlings to plant when they return to the classroom.
-

After getting a little muddy in the mangroves, students rinse off in the ocean.
-

FRIENDS of the Environment's Education Officer, Cassandra Abraham, shows students the seeds from different mangrove species and asks them to identify each one.
-

Our Director of Education, Amy Heemsoth shows students how they are going to plant their mangrove seedings in these plant flats.
-

Forest Heights Academy student holds up his three mangrove seedlings that he is going to plant during today's class.
-

BAM students will plant mangrove seedlings in three different types of media: sand, mangrove mud, and pebbles. Then they will hypothesis which type of media the seedlings grow best in.
-

Dirty Jobs - Forest Heights Academy student starts loading the stinky mangrove mud in the plant flat.
-

Biology student at Forest Heights Academy fills one of the plant flats with pebbles. Students will grow one of their three propagules in this media type.
-

Ready to Grow - Mangrove seedlings in mangrove mud
-

Experiment - Students will grow these mangrove seedlings over the next month to determine which type of media do the mangrove seedlings grow best in.
-

Students test the pH of a liquid using pH paper and then match the color of the pH paper to the chart to determine the pH.
-

FRIENDS of the Environment's Education Officer, Cassandra Abraham, guides students from Forest Heights Academy as they measure the circumference of a tree. Students will measure the circumference of mangroves while on a field trip.
-

Students create the first corner of their square plot by hammering a PVC pipe into the ground.
-

Students at Abaco Central High School pose with their mangrove propagules that they will soon be planting.
-

Abaco Central High School students plant their mangrove seedlings in a flat filled with sand. They too will grow their seedlings in the classroom over the next eight months.
-

Biology students at Abaco Central High School are proud to plant their seedlings in mangrove mud.
-

FRIENDS of the Environment's Education Officer, Cassandra Abraham, helps students plant their mangrove seedlings in pebbles and then label the spot where they are placed in the plant flat.
-

Students at Abaco Central High School hypothesized the media that their seedlings will grow best in: mangrove mud, pebbles, or sand.
-

A brave student from Abaco Central High School fills the plant flat with mangrove mud. It's a dirty job, but she was happy to do it.
-

After an exciting mangrove field trip, students rinse their muddy shoes in the ocean before we head back to Abaco Central High School to plant their mangrove seedlings.
-

Before students from Forest Heights Academy use equipment in the field, they are practicing using it in the classroom first. Here students are placing a sample of liquid on a refractometer to determine the salinity of the liquid.
-

Marine Biology students at Forest Heights Academy test the salinity (salt content) of various types of liquids.
-

During the second year B.A.M. program, students will test several non-living factors in their mangrove plots. Here students are practicing using pH test strips.
-

Ready to Grow - Mangrove seedlings in pebbles
-

B.A.M. 2016-2017 Biology grade 10 participants from Abaco Central High School
-

High tide in the mangroves at Camp Abaco.
-

FRIENDS of the Environment's Education Officer, Cassandra Abraham, shows students the prop roots of the red mangrove tree.
-

Students from Abaco Central High School hesitantly taste the black mangrove leaf only to find out that they are very salty.
-

Abaco Central High School students looking at the salt glands on a white mangrove leaf.
-

Students from Abaco Central High School identify mangrove roots as our Director of Education, Amy Heemsoth point to them.
-

NOAA Knauss Fellow, Symone Johnson helping students at Forest Heights to use a GPS device.
-

Our Director of Education, Amy Heemsoth shows students how to test the pH of various types of liquids.
-

Year 2 B.A.M. participants from Forest Heights Academy, test the pH of various liquids.
-

Playing in the Mud is Fun - Students from Abaco Central High School grade 10 Biology fill the plant flat with mud.
-

Rachel Villani and Tamra Dardenne, Louisiana State University alumni, volunteer to help restore the mangrove ecosystem in Falmouth, Jamaica.
-

Holland High School student helps carry one of the plant flats to the restoration site. Each individual propagule was tagged with flagging tape.
-

Students at Holland High School plant their mangroves carfully in the ground.
-

The mangrove propagules are planted about one inch deep in the soil. This student from Holland High School makes sure that her propagule is firmly planted in the ground.
-

Students from Holland High School take a break and pose for a group photo.
-

William Knibb High School Biology students tag their mangrove seedling with tape, so they can identify which type of media each one was planted in.
-

William Knibb High School Biology students group photo
-

William Knibb High School students get ready to plant their mangrove propagules at the Falmouth restoration site.
-

Students from William Knibb High School are excited to plant their mangroves propagules after caring for them for the past 8 months.
-

William Knibb High School science teachers proudly hold the JAMIN banner after another successful year.
-

William Knibb High School student cradles his mangrove propagule signifying all of the hard work that went into caring for this seedling.
-

Holland High School Biology teacher Cherrida Walters gets her hands dirty and helps her students plant their mangroves.
-

Biology students from Holland High School say goodbye to their baby mangroves.
-

A young lady from Holland High School proudly holds up her mangrove propagules.
-

Heather Brand and Matt Trumbull help to restore the mangroves in Jamaica so that one day their daughter will be able to enjoy this beautiful ecosystem.
-

Kayla Kimmel takes time out from her vacation to restore the mangroves in Falmouth, Jamaica.
-

The students from the JAMIN program planted the shorter trees with the orange tags last year. They have grown so much in just one year!
-

University of the West Indies Discovery Bay Education and Outreach Coordinator, Shanna Thomas, squats to appreciate how much the mangroves have grown since last year.
-

The red mangrove propagules are growing tall at the Falmouth mangrove restoration site.
-

Partners from the University of the West Indies and the Living Oceans Foundation celebrate a day of hard with with volunteer alumni from Louisiana State University.
-

Group photo with students from Holland High School before we restored the mangroves
-

Tenth grade student from Holland High School pauses for a photo before she plants her mangrove propagule.
-

Students from Holland High School plant their mangrove seedlings at the restoration site in Falmouth, Jamaica.
-

Holland High School Biology students plant mangrove seedlings that they have been growing for the past 8 months.
-

Despite the rain, this student from William Knibb High School still has a smile on her face.
-

Hats are not only good for sun protection, but also shelter from the rain. This William Knibb High School student is getting a real-life field experience.
-

B.A.M. 2016-2017 Biology grade 10 participants from Forest Heights Academy.
-

10th grade Biology student traces the red mangrove leaf and labels it with the distinguishing structures.
-

Forest Heights Academy Biology student identifies a red mangrove tree by its leaf.
-

BAM participant from Forest Heights Academy draws a red mangrove leaf in her student journal.
-

Students from Forest Heights Academy taste a black mangrove leaf. Even though it has been raining a lot, the students find out that the leaves are still very salty!
-

Observation is a fact that is learned through one of the five senses: sight, sound, touch, taste, and hearing. Students observe though taste that the black mangrove tree leaves are salty, while having a bit of fun at the same time.
-

Forest Heights Academy student draws a black mangrove leaf and labels the salt and fine hairs on the leaf.
-

10th grade Biology student draws leaves of the black, red, and white mangrove tree to help him later remember how to identify each.
-

Students at Forest Heights Academy finish drawing each of the mangroves leaves.
-

A trip to the mangroves wouldn't be complete without a walk in the mud.
-

Our Director of Education, Amy Heemsoth teaching 10th grade Biology students about the basics of mangroves at Forest Heights Academy.
-

Forest Heights Academy's Marine Biology Class ready to jump into action to create mangrove plots for future monitoring.
-

William Knibb High School student sings a song in thanks for the Foundation providing the opportunity for students from their school to participate in the JAMIN program.
-

Students excitedly crowd around a science teacher from William Knibb High School for a quick photo.
-

Students from William Knibb High School find an open spot to plant their mangrove propagules. These students know that the propagules need space to grow.
-

Here is the aftermath of the restoration - orange, pink, and yellow tagged propagules!
-

Last year, students in the JAMIN program planted these black mangroves (tagged in orange). They are very healthy and growing tall.
-

Amy Heemsoth, the Foundation's Director of Education, proudly hands out certificates of partipation to the students at William Knibb High School
-

Amy Heemsoth, the Foundation's Director of Education, and William Knibb High School Biology teacher Fulvia Nugent, conduct a short JAMIN award ceremony for the students.
-

Amy Heemsoth, the Foundation's Director of Education, proudly hands out certificates of partipation to the students at William Knibb High School
-

Amy Heemsoth Director of Education for the Foundation and Fulvia Nugent Biology Teacher at William Knibb High School celebrate another successful year of the JAMIN program.
-

Students at William Knibb High School hold up their certificates to celebrate a successful end of the JAMIN program.
-

William Knibb High School student sang a song in thanks for the JAMIN program. She is photographed here with the Foundation's Director of Education, Amy Heemsoth.
-

Forest Heights Academy students collect red mangrove propagules at Camp Abaco.
-

Ryann Rossi, PhD Candidate at North Carolina State University helps a student at Forest Heights Academy to isolate a piece of his diseased mangrove leaf.
-

Although it is hot, students at William Knibb High School are determined to collect the data that they need to monitor their mangroves.
-

11th grade Biology student at William Knibb High School uses a core sampler to take a sample of soil from his mangrove quadrat. Later, he and his group will use a sieve to determine the size and quantity of the particles in the soil sample. Using a chart, the students will determine the type of soil that is in their plot (i.e. clay, sand).
-

J.A.M.I.N. year 2 student from William Knibb High School prepares to use a GPS. The student will record the location of the mangrove trees that he and his group are monitoring in their mangrove plot and later the students will map the mangroves.
-

William Knibb student uses a paint pen to mark the location where she will measure the circumference of the mangrove tree trunk. This mark will be used to accurately measure the circumference in the future.
-

Student groups at William Knibb High School work together to collect and record data in their mangrove plot. This student is explaining to his classmate that he has recorded the latitude and longitude of one of the mangrove trees in their plot.
-

Biology grade 11 teacher and science department head, Fulvia Nugent has participated in the J.A.M.I.N. program for the past three years and she is still excited every time that she goes to the mangroves with her students.
-

Student from William Knibb High School measures the salinity of the water in her quadrat using a refractometer.
-

William Knibb High School student uses a refractometer to record the salt content or salinity of water in her mangrove plot.
-

J.A.M.I.N. year 2 student from William Knibb High School familiarizes himself with using a clinometer, which is a tool used to help determine the height of trees.
-

Student from William Knibb High School takes the initiative to record data for his group.
-

Classmates at William Knibb High School work together to collect and record data about their mangrove plot.
-

Students work as teams to set up and monitor their mangrove quadrats. This team from William Knibb High School is ready to collect some data.
-

During the second phase of the year 2 program, this student from William Knibb High School identifies the mangrove species and measures the circumference and height of the mangrove trees in their quadrat.
-

Forest Heights Academy student isolates two pieces of his diseased mangrove leaf. These leaf pieces will now be placed in an agar plate.
-

A potentially diseased leaf that has been dissected by a Forest Heights Academy student for the B.A.M. year 2 disease experiment.
-

Forest Heights Academy student sterilizes a pair of tweezers before she picks up her mangrove leaf isolations and places them in an agar plate.
-

Students at Forest Heights Academy further sterilize the mangrove leaf isolations by placing them in a bleach solution for several seconds before transferring them to their agar plate.
-

Science is fun especially when you get to use interesting scientific tools and different methods!
-

To prevent bacterial contamination, Ryann Rossi, PhD candidate at North Carolina State University shows students how to seal their agar plates with Parafilm.
-

Here are a couple of proud Forest Heights Academy students who have completed isolating and plating their potentially diseased mangrove leaves.
-

Forest Heights Academy student drawing of a potentially disease mangrove leaf that has multiple lesions. Throughout the B.A.M. program, we try to include components of S.T.E.A.M. (Science, Technology, Engineering, Art, and Math).
-

Here is an interesting mangrove leaf that one of the students picked up. It is believed that this leaf was damaged by insects.
-

J.A.M.I.N. year 2 student from William Knibb High School measures the temperature of the soil inside his quadrat.
-

As part of the year 2 J.A.M.I.N. program, students collect soil samples to determine the soil texture in their mangrove plot. They collect the soil using a soil corer like the one photographed.
-

William Knibb High School student shows off her soil sample before she labels and places it in her collection bag. Later she and her group will determine the contents.
-

The J.A.M.I.N. students mangrove seedlings look very healthy, especially the ones growing in mud. In the past, we have had trouble with boring bugs damaging the propagules.
-

Students at William Knibb High School can barely wait to hear about the mangrove organisms that we brought in for "show-and-tell." Many students are seeing and touching these organisms for the first time.
-

10th grade biology student from William Knibb High School is excited to be able to hold a sea biscuit. Notice how the sea biscuit is using sand and pieces of shell to camouflage itself.
-

William Knibb High School students touch a sea biscuit for the first time. Students note the bristles on the organisms and they observe how that the sea biscuit uses them to camouflage itself and move.
-

Students touch a sea cucumber. One student noted that the sea cucumber is slimy and squishy. She wasn't expecting that.
-

Shanna Thomas, Outreach Officer at the University of the West Indies allows students at William Knibb High School to hold sea urchins. She discusses how they are related to sea cucumbers, sand dollars, and sea stars.
-

William Knibb science teacher, Fulvia Nugent enjoys participating as much as the students do. She moderates by holding the animals so that students can touch and hold them.
-

William Knibb science teacher, Fulvia Nugent holds a sea urchin so that other students can get a chance to touch the organism. She holds the sea urchin upside-down so that students can see the mouth located at the center.
-

Students at William Knibb High School listen to Shanna Thomas talk about the anemone in the glass container. Students are not allowed to touch this delicate animal, however, Shanna waves her fingers in the tentacles so that the students can see how the anemone reacts to motion.
-

Some William Knibb High School students stick around after school to continue to learn more about the organisms that we brought into their classroom as part of the J.A.M.I.N. food web curriculum.
-

The J.A.M.I.N. program is conducted using project-based learning. Typically, for eight months, students grow mangrove seedlings in the classroom in three different types of media: sand, mangrove mud, and pebbles. The students measure the growth of their propagules and then at the end they determine which media was the best type for mangrove seedlings to grow in.
-

In the J.A.M.I.N. year 1 program, students grown mangrove seedlings in the classroom from September until May. This year, due to Hurricane Matthew, we started in November, so the propagules are not as tall, but they are still growing tall.
-

Here is the document with the location for each students' propagules in the plant flats.
-

A student from William Knibb High School carefully measures the trunk of a mangrove tree as part of the year 2 J.A.M.I.N. program.
-

J.A.M.I.N. participant from William Knibb High School stands by ready to record data that her group is collecting.
-

Director of Education, Amy Heemsoth finds evidence that there is some type of bug feasting on the mangrove leaves at the Falmouth Restoration site.
-

Fulvia Nugent proudly helps this group of students monitor their mangroves. This is the second year in a row that these students from William Knibb have partipated in the J.A.M.I.N. program.
-

J.A.M.I.N. participants from William Knibb High School gladly take a moment from collecting data to pose for a team photo.
-

William Knibb High School students dig a hole to collect water from their mangrove plot. The students will measure the salinity, dissolved oxygen, and pH of the water.
-

These ladies from William Knibb High School use a pipette to place a couple of drops of salt water on a refractometer so they can measure its salinity.
-

Collecting soil samples when the ground is hard and dry is a tough task; however, this student from William Knibb High School managed to collect a large sample.
-

Sometimes there are equipment failures in the field. This student from William Knibb High School realizes that her refractometer is not giving her a correct reading. The equipment needs to be recalibrated, but in the meantime the student borrows another refractometer.
-

Seville Heritage Park has partnered with the University of the West Indies and the Living Oceans Foundation to provide mangrove education to area high school students. This photo is of the great house at Seville Heritage Park, which serves as a museum. The Seville property consists of 300 acres of property that allows visitors to explore Jamaica's history and culture.
-

William Knibb 10th grade Biology student gets up close and personal with a sea urchin. She as fascinated by the tube feet that help the organism to move.
-

Abaco Central High School student has found all of her mangrove propagules. Now she is ready to plant them.
-

Wiliam Knibb High School J.A.M.I.N. year 2 participants at Falmouth mangrove site.
-

Student from William Knibb High School assists with the recovery of the drone.
-

Students from William Knibb High School were excited to help recover the drone after taking aerial shots of the mangrove forest.
-

Coal burning in Jamaica - mangrove and other trees are cut down and burned to make coal for local hotel and personal consumption.
-

It's time to return the sea hares back to the ocean. The students were really excited to see these unusual creatures.
-

The day that we collected animals was really windy and their were white caps everywhere, but when we returned back to our collecting spot, we couldn't have asked for a better day. It also makes for a much easier transition for the animals.
-

Ryann Rossi, PhD Candidate at North Carolina State University
-

Ryann Rossi, PhD Candidate at North Carolina State University explains the disease symptoms that the students should be looking for when collecting leaves from their quadrat.
-

Ryann Rossi, PhD Candidate at North Carolina State University explains how students should label their collecting bags. She also mentions that the students need to make sure that their ziploc bags are sealed so that we do not risk spreading the disease to other mangroves.
-

Ryann Rossi, PhD Candidate at North Carolina State University explains the disease symptoms that the students should be looking for when collecting leaves from their quadrat.
-

A red mangrove tree with black mangrove pneumatophores (looks like sticks) popping out of the ground.
-

Videographer Art Binkowski films an interview with Scientific Officer, Camilo Trench from the University of the West Indies Discovery Bay Marine Lab.
-

Red mangroves near the waters edge at the Falmouth mangrove forest.
-

Forest Heights Academy student read instructions for how to take a pH and dissolved oxygen sample from their mangrove plot.
-

B.A.M. second year student reads the salinity of the mangrove ecosystem using a refractometer.
-

Forest Heights Academy student measures the temperature of the soil in her mangrove plot.
-

Red mangroves at our new mangrove site at Seville Heritage Park in St. Ann's Bay.
-

Students from Marcus Garvey Technical School going on their first mangrove field trip to learn about this unique ecosystem.
-

10th grade Biology student from Marcus Garvey Technical School draws and labels the leaves of the three different mangrove trees in Jamaica.
-

Marcus Garvey Technical School J.A.M.I.N. participants at Seville Heritage Park mangroves.
-

Mangrove propagules (seedlings) that were planted during the first year of the J.A.M.I.N. program.
-

One of the many animals that lives in the mangroves – a fiddler crab.
-

Propagules (seedlings) from the black mangrove tree.
-

Red mangroves line the intertidal zone at Camp Abaco. Notice the many red mangrove seedlings that have taken root here.
-

Forest Heights Academy 12th grade Marine Biology student collects a soil sample from his group's quadrat.
-

Forest Heights Academy students get a chance to touch the agar in a test plate to see what it feels like. Most students have never touched or seen agar before. Students will not be able to touch the agar in their own plates or else they will contaminate their samples.
-

Before students begin "plating" their potentially disease leaves in agar, they first must draw their leave and label the areas where there are lesions present.
-

Partner from North Carolina State University, Ryann Rossi helps students to set up and sterilize their station.
-

FRIENDS of the Environment Outreach Officer, Cassandra Abraham helps Forest Heights Academy student to cut a small section of his potentially diseased mangrove leaf that includes diseased and non-diseased sections of the leaf.
-
Students at Forest Heights Academy label their agar plates so that they can later check their plates after 3 days, 1 week, and 2 weeks to see if there is any type of fungus growing.
-

Here is an example of a diseased mangrove leaf drawing from a student at Forest Heights Academy.
-

Students at Forest Heights Academy sterilize their tools before isolating the diseased portion of their mangrove leaves. Students will grow these isolations in agar plates to see if there is fungal growth present, which could indicate that the mangroves are diseased.
-

Students at Forest Heights Academy sterilize tweezers and scissors over an open flame before they use them to cut or pick up the diseased mangrove leaves. This prevents contamination.
-

Student at Forest Heights decontaminate a pair of tweezers by burning it over an open flame.
-

B.A.M. year 2 student from Forest Heights Academy proudly shows off his plated mangrove leaf. Now all he has to do is wait to see if fungus will begin to grow.
-

Ryann Rossi, PhD Candidate at North Carolina State University explains to Forest Heights Academy students how they will isolate the potentially diseased lesions on their leaves.
-

Ryann Rossi, explains the symptoms of disease that is often seen in plants and even the mangrove trees. The most common symptom in mangrove trees in the Bahamas is necrotic or dead tissue.
-

Before the students begin the disease activity, Ryann Rossi provides a short presentation about the mangrove disease, the types of disease, and how they plants can contract disease. During the presentation, students take notes in their Mangrove Journals.
-

Marine Biology student from Forest Heights Academy takes the soil temperature inside her quadrat. At the end of the year, students will compare the three sets of data that they collected while on BAM field trips.
-

BAM year 2 students from Forest Heights Academy wade into the mangrove mud to sample the pH and dissolved oxygen in their quadrats.
-

Forest Heights Academy group members take a time out from monitoring their mangroves to pose for a photo.
-

Students at Forest Heights Academy that are in the year 2 program work in teams of 5-6 people in order to monitor the mangroves in a 5 x 5 meter area.
-

Year 2 B.A.M. students measure the amount of dissolved oxygen in the water of their mangrove quadrat. Dissolved oxygen is the amount of oxygen in water. It is important to measure dissolved oxygen because it is necessary for aquatic forms of life.
-

Forest Heights students record their data in the mangrove journals.
-

B.A.M. student collects a water sample inside his mangrove plot. He will measure the temperature, dissolved oxygen, salinity, and pH of the water.
-

Forest Heights student collected a sample of water to measure the salinty or the amount of salt in the water in her mangrove quadrat.
-

Ryann Rossi, PhD Candidate at North Carolina State University explains the basics of plant disease with B.A.M. year 2 students at Forest Heights Academy.
-

As part of the B.A.M. year 2 program, the students are learning about mangrove disease in the Bahamas and participating in ongoing science being conducted by Ryann Rossi, PhD candidate at North Carolina State University.
-

Forest Heights Academy Marine Biology student carefully uses a scalpel to cut or isolate a small piece of his diseased mangrove leaf. The student will place the leaf in agar and wait to see if fungus grows.
-

Lauren Thayer, Lousiana State University Alumni, plants mangrove trees at the JAMIN mangrove restoration site in Falmouth, Jamaica.
-

Showing off wares at the fish market.
-

Tu'anekivale girls excited to greet us.
-

We got a warm welcome at GPS Tu'anekivale.
-

Students at GPS Tu'anekivale making funny faces for the photographer.
-

GPS Tu'anekivale student playing tag.
-

GPS Tu'anekivale students posing for the camera.
-

GPS Tu'anekivale students having fun during recess.
-

Students at GPS Tu'anekivale enjoying a camera shoot.
-

Excited students at William Knibb High School ask for a photo with a sea anemone.
-

William Knibb student (on the right) is explaining to her classmate that there are mirrors inside the microviewer that reflect the image of the animals inside.
-

Students at William Knibb High School gently hold a sea cucumber and they mention that it feels slimmy.
-

William Knibb students take a break from looking at mangrove organisms to take a group photo.
-

William Knibb student holds sea anemone and laughs as the tube feet start to move tickling his hand.
-

10th graders at William Knibb High School check out marine snails.
-

Purple-tipped anemone that we brought to Holland and William Knibb high schools as part of a "What Lives in the Mangroves?" activity.
-

Biology students at Holland High School touch an anemone and find out that the tentacle are quite sticky.
-

JAMIN participants at Holland High School check out the small structures of a lettuce sea slug in the microviewer.
-

Holland High School grade 10 biology students concentrate on listening to a presentation about mangrove food webs.
-

GPS Tu'anekivale young student playing hide and seek.
-

GPS Tu'anekivale students enjoying popsicles on a hot day.
-

GPS Koloa student playing cards at recess.
-

Students from GPS Liviela enjoying their lunch break in the cool shaded area.
-

Boys at Vava'u Side School came to tell us goodbye.
-

Vava'u Side School students happy to take a break from jumping rope to take a photo.
-

Vava'u Side School students jumping rope at recess.
-

St. Peter Chanel students concentrating hard while taking coral reef survey.
-

Tongan kids who created makeshift plastic "sleds."
-

When you are a tropical island nation that never gets snow, why not "sled" down a hill?
-

Students at Mailefihi Siu'ilikutapu College listening to 'Apai give instructions.
-

Mailefihi Siu'ilikutapu College students taking coral reefs survey.
-

Plumeria.
-

Girls tending to a local food stand.
-

Students at Sanieha High School taking coral reef survey.
-

Melinda admiring the sights.
-

Mangroves near Koloa community in Vava'u.
-

Red mangroves of Vava'u.
-

GPS Koloa students taking a break from their school work.
-

GPS Koloa students taking survey about coral reefs.
-

During a JAMIN professional development session, our Director of Education Amy Heemsoth describes the various type of macroalgae (seaweed) and their role in sand production.
-

Fulvia Nugent, William Knibb High School JAMIN teacher, learns about sea cucumbers during a teacher training session.
-

Local dancers provide entertainment at the farmer's marker
-

A woman weaving dried pandanus leaves at the farmer's market
-

Students at GPS Liviela
-

University of the West Indies partner, Camilo Trench, explains how sea stars, sea urchins, sand dollars, and sea cucumbers are part of the Phylum Echinodermata.
-

UWI Discovery Bay partner, Camilo Trench, teaching students from William Knibb High School about black mangroves.
-

A student holds up a fiddler crab, one of many species that makes its home in Jamaican mangrove forests.
-

Camilo Trench finds a tiny crab crawling around and though unexpected, he teaches students how small animals often live on other organisms like sponges and seaweed.
-

Students taste a mangrove leaf -they're salty!
-

A student shows off his sketch of a mangrove leaf.
-

Students show off mangrove leaves they collected.
-

William Knibb student taking a closer look at turban snails. They have two antennae that help them to feel around their surroundings.
-

William Knibb high schoolers learn about the different trophic levels in the mangrove food web. These two students (macroalgae and phytoplankton) are primary producers meaning they create their own food.
-

William Knibb students show off the food web animals that they represent.
-

William Knibb student stands next to the mangrove propagules to show the scale.
-

A student answers questions on her activity worksheet while on a field trip to a mangrove forest.
-

This student was so excited to hold a crab for the first time.
-

Students use yarn to create a mangrove food web or a series of interconnected food chains.
-

Sunset over Neiafu harbor in Vava'u
-

Boys at Vava'u High School
-

Boys at Vava'u High School
-

A brittle star, a type of starfish, that we showed to teachers and students when talking about the organisms that live in the mangroves.
-

Holland High School teachers, Cherrida Walters-Jackson and Gregory Peart examine a sea cucumber during professional development training.
-

Teachers at Willliam Knibb High School holding a sea urchin. Fulvia Nugent (right) is one of our JAMIN teachers.
-

Friends at GPS Tu'anekivale preparing to listen to a presentation about coral reefs
-

GPS Tu'anekivale student posing for a picture
-

Students at GPS Tu'anekivale enjoying recess
-

GPS Tu'anekivale school photo
-

Student at GPS Tu'anekivale taking coral reef survey
-

GPS Tu'anekivale student taking coral reef survey
-

Students at GPS Tu'anekivale diligently taking coral reef survey
-

Mizpah student taking her time to answer survey questions
-

Students at Mizpah High School taking educational survey
-

Sunset of Neiafu Harbor in Vava'u
-

Director of Education enjoying taking selfie photos with students from GPS Neiafu
-

GPS Neiafu student taking survey about coral reefs
-

Young girl taking survey about coral reefs from GPS Neiafu
-

Boys at Vava'u High School
-

The fishing boats in Neiafu Harbor in Vava'u.
-

Students at Abaco Central High School carefully touch sea urchins for the first time.
-

An inquisitive student at Forest Heights Academy observes the behavior of a sea star. She had many questions for us.
-

Students at Forest Heights Academy form a mangrove food web.
-

Students at Abaco Central High School participate in a food web activity. Each student is given an animal or plant that can be found in the mangrove food web. A young lady shows that she will be portraying turtle seagrass.
-

Students at Abaco Central High School are excited to plant their mangrove seedlings after nurturing them for the past 7 months.
-

Before planting the mangrove propagules, student must wade out into the mangrove mud. This Abaco Central High School student generously carries the mangrove seedlings to their new home.
-

Abaco Central High School Biology students plant mangrove seedlings restoring an area near Camp Abaco.
-

Student from Abaco Central High School plants a mangrove propagule.
-
Students at Abaco Central High School and our Director of Education, Amy Heemsoth (center) celebrate restoring the mangrove ecosystem at Camp Abaco.
-

Students at Forest Heights Academy hold a sea urchin, sea star, and sea cucumber, which they learned are animals that are in the Phylum Echinodermata.
-

Here is a close-up view of the sea star's tube feet. The sea star is being held upside down.
-

FRIENDS Program Assistant AJ McIntosh allows students to hold sea stars and sea urchins, so that students at Forest Heights Academy can feel the tube feet moving on their hands.
-

FRIENDS Program Assistant AJ McIntosh and Abaco Central Alumni, shows students where the tube feet are located on a sea star.
-

Students at Abaco Central High School learn about macroalgae, which is better known as seaweed. As the students feel the rigidity of the macroalgae, Amy Heemsoth, our Director of Education, explains that many species of macroalgae obtain calcium carbonate in their structure. When they die, the calcium carbonate is broken down and helps to create more sand.
-

Forest Heights Academy students are excited to see a pufferfish. The next step is for them to use books to identify the species.
-

FRIENDS Education Officer Cassandra Abraham helps a student at Forest Heights to identify a sea urchin.
-

An 11th grader at Forest Heights Academy checks out a decorator crab.
-

10th grade biology students at William Knibb High School.
-

Discovery Bay Marine Lab Outreach Officer, Shanna Thomas discusses how brittle stars feed to students at William Knibb High School.
-

Students at William Knibb High School are in awe at how the brittle star moves its arms back and forth like a snake, in order to move.
-

Red mangrove trees dominate the area around Camp Abaco where students participating in the B.A.M. program will plant their red mangrove seedlings.
-

FRIENDS of the Environment intern, Christian McIntosh helps to tag each of the mangrove propagules with orange so that we can monitor their growth and health.
-

The red mangrove propagules are all tagged with different colored tape, which represents the various types of media that they grew in: mangrove mud, pebbles, and sand.
-

Forest Heights Academy student plants her last seedling.
-

One of 135 red mangrove propagules that the students planted in the mangrove swamp during the B.A.M. program.
-

Forest Heights Academy student readjusts the position of her mangrove seedling in the mud, so that the lenticels that allow for gas exchange are exposed to the air.
-

Even after sinking in the mud, this Forest Heights Academy student is excited to plant her mangroves.
-

Forest Heights Academy Biology teacher, Lindsey Borsz helps students plant mangrove trees.
-

Even though this Forest Heights Academy student was hesitant about walking in the mangrove mud, she did it anyway and with a smile on her face!
-

Director of Education, Amy Heemsoth, teaching Holland High School students how to graph their mangrove propagule growth data.
-

Alumni from Louisiana State University volunteer during their vacation to help remove old stumps and level soil at the JAMIN mangrove restoration site.
-

Forest Heights Academy student tries to secure the squishy mud around her propagule to stabilize it.
-

Forest Heights Academy 12th grader is excited to be on a fieldtrip planting his mangrove propagules.
-

Forest Heights Academy student collects her and her friends mangroves and she is ready to plant them.
-

The red mangrove progagules were well cared for by the students. They grew nice and tall over the past 7 months.
-

Red mangrove trees, like the seedlings the students have been growing, are often referred to as "walking trees" because of their large propped roots.
-

Abaco Central High School students prepare to plant their first mangrove seedling.
-

Abaco Central High School students spread out so that they give their mangrove seedlings a large area to grow.
-

Forest Heights Academy is ready to plant their mangrove seedlings.
-

Forest Heights Academy Biology teacher, Lindsey Borsz bounces into action, ready to plant the mangroves.
-

Marine Science students at Forest Heights Academy say goodbye to their mangrove propagules that they have been caring for the past 7 months.
-

11th grade Marine Science students at Forest Heights Academy are getting ready to plant their mangroves.
-

Volunteer Kayla Kimmel helps plant mangroves at the JAMIN mangrove restoration site in Falmouth, Jamaica.
-

Palm trees.
-

Here at Abaco Central High School, we are using microviewers to magnify the small animals inside, so that we can take a closer look at the features of the animal.
-

Our Director of Education Amy Heemsoth teaching students at Abaco Central High School about food webs.
-

Amy Heemsoth, our Director of Education, shows the various characteristics of the Phylum Porifera. She is holding a sponge in her hand, which are the animals that are found in this phylum.
-

Our Director of Education Amy Heemsoth holds up a small decorator crab. She explains that this crab is able to put objects like sponges, rocks, and algae on it's back to camouflage its body.
-

Students at GPS Liviela peaking at the courtyard to see what was going on.
-

Science teachers at William Knibb and Holland High Schools take a peak at various mangrove animals.
-

Science teachers lean over the tanks to take a closer peak at a sea anemone.
-

During professional development training, William Knibb science teachers hold a brittle star for the first time.
-

Lindsey Borsz, science teacher at Forest Heights Academy, takes a closer look at the upside-down jellyfish, an animal found in the mangrove ecosystem. These jellyfish have symbiotic algae that live in their tentacles. They point their tentacles towards the sun, so the algae can photosynthesize, producing nutrients for the jellyfish.
-

Photographed are some creatures that live in the mangroves including sea stars, sea cucumbers, sea urchins, and a tulip snail.
-

Everyone loves the selfie stick at GPS Liviela!
-

Selfies with students at Mizpah High School.
-

Amy, Melinda, and 'Apai at Mailefihi Siu'ilikutapu College.
-

Amy and Melinda with beautiful Neiafu Harbor behind them.
-

Teachers from Abaco Central High School and Forest Heights Academy enjoy identifying marine animals during professional development training at FRIENDS Kenyon Center Lab.
-

Michelle Bailey, science teacher at Abaco Central High School observes marine snails through a microviewer at FREINDS Kenyon Center Lab.
-

One of the many creatures that we brought to the professional development training at FRIENDS Kenyon Center Lab and the classes. Photographed is a bristle worm magnified through a microviewer. Notice the toxic bristles on each side.
-

James Richard, Michelle Bailey, and Lindsey Borsz holding sea stars and sea cucumbers. These educators identified organisms in the mangroves as part of a professional development training at FRIENDS Kenyon Center Lab.
-

Gregory Peart, agriculture teacher at Holland High School holds a brittle star.
-

Discovery Bay Research Laboratory Outreach Officer, Shanna Thomas, explains the anatomy of a brittle star.
-

Discovery Bay Marine Lab Chief Scientist, Camilo Trench, provides instructions for the food web activity explaining that each person represents a different organism in the mangrove food web.
-

JAMIN teacher, Cherrida Williams-Jackson has a great time participating in a mangrove food web activity. This is her first time participating in the JAMIN program.
-

Amy Heemsoth, our Director of Education, draws the water vascular system of a starfish to help students at William Knibb High School to understand how these animals move.
-

Students at William Knibb High School hold a sea anemone for the first time and they are intrigued by this animal.
-

Discovery Bay Research Laboratory Outreach Officer, Shanna Thomas, teaches students at William Knibb High School about sea cucumbers and how they can eject their internal organs to escape predators and then later grow them back.
-

A young woman at William Knibb High School examines a sea cucumber more closely. She said that she had never seen one before.
-

Student at Abaco Central High School looks through a microviewer to get a better look at a decorator crab.
-

Amy Heemsoth, our Director of Education, shows students at Abaco Central High School how chitons are able to attach themselves to rocks.
-

The upside jellyfish intrigues students at Abaco Central High School. Students know not to touch this stinging creature.
-

10th grader at Holland High School pretends to be phytoplankton (a plant-like plankton) during a food web activity.
-

Science teacher at William Knibb High School gets a magnified look at a fire worm during a professional development session.
-

The red mangrove seedlings that the students planted in September here at Abaco Central High School are growing tall. The question is, "Which ones will grow the fastest? The seedlings planted in mangrove mud, sand, or pebbles?"
-

Holland High School students are shocked that some of the organisms, like sea cucumbers, can live near the mangroves.
-

Discovery Bay Marine Lab Chief Scientist, Camilo Trench, describes the characteristics of sponges to students at Holland High School.
-

Ryann Rossi, PhD Candidate at North Carolina State University explains the disease symptoms that the students should be looking for when collecting leaves from their quadrat.
-

Young girl waiting for the education program in Kia Village.
-

As part of Ryann Rossi's mangrove study, she found signs of diseased mangroves at Camp Abaco. BAM students also found signs of disease on the mangroves located at Camp Abaco.
-

Some young girls of Bareho Village pose for a photograph.
-

The warm welcome of a smile from a young girl in Nazareth community.
-

Mangrove scientist, Ryann Rossi, posing with the specimens that she studies - mangroves.
-

Ryann Rossi, PhD Candidate at North Carolina State University explains how students should label their collecting bags. She also mentions that the students need to make sure that their ziploc bags are sealed so that we do not risk spreading the disease to other mangroves.
-

Young children of Nazareth community.
-

A young child paddles around in his dugout canoe.
-

Students participating in year 2 of KSLOF's mangrove education and restoration program.
-

As part of the B.A.M. year 2 program, the students are learning about mangrove disease in the Bahamas and participating in ongoing science being conducted by Ryann Rossi, PhD candidate at North Carolina State University.
-

A young child in Nazareth community handlines for fish from the dock.
-

Ryann Rossi, PhD Candidate at North Carolina State University explains to Forest Heights Academy students how they will isolate the potentially diseased lesions on their leaves.
-

A young boy in Bareho Village is excited to start school.
-

In the early morning, a woman near Seghe was handlining for fish.
-

Before the students begin the disease activity, Ryann Rossi provides a short presentation about the mangrove disease, the types of disease, and how they plants can contract disease. During the presentation, students take notes in their Mangrove Journals.
-

Forest Heights Academy student drawing of a potentially disease mangrove leaf that has multiple lesions. Throughout the B.A.M. program, we try to include components of S.T.E.A.M. (Science, Technology, Engineering, Art, and Math).
-

Today’s catch in Gizo Island.
-

Solomon Islands tropical oasis near Morovo Lagoon.
-

Students cut sections of mangrove leaves for plating.
-

Sisters near Titiana Village, Gizo Island.
-

Mangrove leaf with sections removed for further study.
-

Primary students gather around at Dunde School.
-

A potentially diseased leaf that has been dissected by a Forest Heights Academy student for the B.A.M. year 2 disease experiment.
-

FRIENDS of the Environment Outreach Officer, Cassandra Abraham helps Forest Heights Academy student to cut a small section of his potentially diseased mangrove leaf that includes diseased and non-diseased sections of the leaf.
-

Patututiva Community listening to LOF coral reef education program.
-

Students at Forest Heights Academy sterilize tweezers and scissors over an open flame before they use them to cut or pick up the diseased mangrove leaves. This prevents contamination.
-

Nazareth Village near Morovo Lagoon.
-

Family posing for a photo together.
-

Mangroves of the Solomon Islands
-

Lady of Kia Village preparing fish.
-

Ryann Rossi, PhD Candidate at North Carolina State University helps a student at Forest Heights Academy to isolate a piece of his diseased mangrove leaf.
-

Partner from North Carolina State University, Ryann Rossi helps students to set up and sterilize their station.
-

Kids in Kia Village enjoying a vacation day from school.
-

Students at Forest Heights Academy label their agar plates so that they can later check their plates after 3 days, 1 week, and 2 weeks to see if there is any type of fungus growing.
-

Kids in Gizo cooling off from the hot afternoon sun.
-

Kids enjoying a feast in Kia Village.
-

Here are a couple of proud Forest Heights Academy students who have completed isolating and plating their potentially diseased mangrove leaves.
-

It looks like these students from Forest Heights Academy have found more than enough mangrove seedlings to plant when they return to the classroom.
-

Kia Village
-

Plating leaves
-

Fungus from the leaves will grow on agar
-

The houses in Kia Village overlook patch reefs.
-

The red mangrove propagules are all tagged with different colored tape, which represents the various types of media that they grew in: mangrove mud, pebbles, and sand.
-

Mangrove Detecti
-

The children were racing their dugout canoes.
-

FRIENDS of the Environment intern, Christian McIntosh helps to tag each of the mangrove propagules with orange so that we can monitor their growth and health.
-

Students at Abaco Central High School are excited to plant their mangrove seedlings after nurturing them for the past 7 months.
-

DSC_5913
-

Kia village boys in relaxing in their dugout canoes.
-

The houses in Kia Village are mostly build over the water.
-

Even though this Forest Heights Academy student was hesitant about walking in the mangrove mud, she did it anyway and with a smile on her face!
-

Students show off their science project
-

The groundtruthing team mapping near Gizo Island.
-

Mangrove Detectives at work
-

William Knibb High School Biology students group photo
-

Gizo students enjoying their afternoon school vacation.
-
Plated leaf cuttings
-

Students from Holland High School plant their mangrove seedlings at the restoration site in Falmouth, Jamaica.
-
Fungus growing on agar growth plates
-

Fish market in the town of Gizo.
-

B.A.M. year 2 student from Forest Heights Academy proudly shows off his plated mangrove leaf. Now all he has to do is wait to see if fungus will begin to grow.
-

Gizo fishing boats.
-

Fruit and vegetable market in Gizo.
-

Friends from Patutiva Community.
-

During an LOF education program, Ivory Akao, Fisheries Officer, explains that corals produce a skeleton made of calcium carbonate.
-

Joao Monteiro practices flying the drone in Gizo.
-

Rob Gardiner of the groundtruthing team ready to put the dropcam in the water.
-

Community in Morovo Lagoon.
-

Children of Kia Village wait for our arrival.
-

A calm day to visit Seghe.
-

Children of Gizo.
-

Boys near Seghe town stop for a quick photo opportunity.
-

Boy from Patutiva Community near Morovo Lagoon.
-

Boy from Patutiva Community near Morovo Lagoon.
-

Boy from Chuchulu Village near Morovo Lagoon.
-

A found farewell from the children of Kia.
-

Young man hanging out near the fish market in Ghizo Island.
Go to page:
Articles
-
2021
Published in Current: The Journal of Marine Education Abstract Black Girls Dive Foundation (BGDF) was established to empower and inspire young girls to explore their STEM (Science, Technology, Engineering and Mathematics) identities through aquatic-based STEM activities and ocean stewardship. BGDF’s STREAMS …
-
2021
Global Reef Expedition Final Report
The Global Reef Expedition Final Report summarizes the findings from our 10-year research mission to survey and map coral reefs across the Atlantic, Pacific, and Indian Oceans as well as the Red Sea. The Expedition involved hundreds of research scientists …
-
2017
Global Reef Expedition Final Report: Fiji
The Khaled bin Sultan Living Oceans Foundation is conducting the Global Reef Expedition – the largest coral reef survey and mapping expedition in history. The Global Reef Expedition is a five-year mission to survey the health and resiliency of coral …
-
2016
This article written by Amy Heemsoth (KSLOF Education Director) about the KSLOF Mangrove Program in Jamaica and The Bahamas was recently featured in Seven Seas Magazine. Planting the [Mangrove] Seed Seven Seas Magazine August 1, 2016 Amy Heemsoth As I quietly walk …
Go to page: